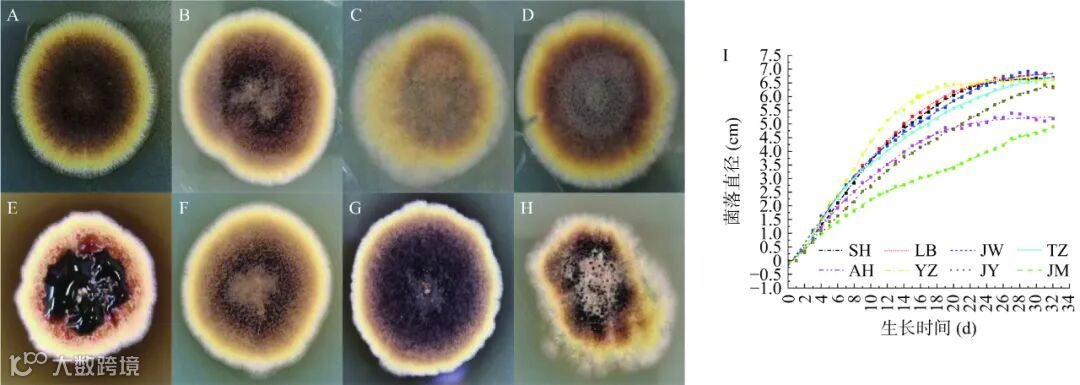

EI收录,
入选中国科技期刊卓越行动计划
摘要
从8种市售黑茶中分离和鉴定冠突散囊菌,并固态发酵苦荞籽粒。测定发酵前后的营养物质总淀粉、可溶性蛋白、脂肪、还原糖,以及功能成分总黄酮和总多酚的含量,并分析两种重要生物转化酶(苯丙氨酸解氨酶和多酚氧化酶)的活性以及与营养功能成分间的关系,以比较不同冠突散囊菌对苦荞营养功能成分的转化作用。结果表明,分离菌中7株为冠突散囊菌,1株为谢瓦氏曲霉;经冠突散囊菌发酵后,苦荞籽粒营养物质中的总淀粉、可溶性蛋白和脂肪含量皆显著低于发酵前(P<0.05),而还原糖以及功能成分总黄酮和总多酚的含量多数显著高于发酵前(P<0.05);总黄酮含量较高的为LB和YZ菌株,总多酚含量较高的为JW和YZ菌株。相关性分析显示,发酵苦荞的总黄酮、总多酚分别与苯丙氨酸解氨酶、多酚氧化酶活性呈极显著正相关(P<0.001),而还原糖和总淀粉呈极显著负相关(P<0.001),提示发酵苦荞营养物质的变化与冠突散囊菌的生物转化过程密切相关。本研究为基于益生菌发酵工艺开发新型苦荞产品提供了理论依据。
冠 突 散 囊 菌( Eurotium cristatum,简 写为 E. cristatum)是散囊菌属的一种好氧性真菌,无性型称为冠突曲霉(Aspergillus cristatus,简写为 A. cristatus),具有耐干燥、耐渗透压的特性,在土壤、茶叶、海洋等中有分布。冠突散囊菌是茯砖茶制作过程中的关键优势真菌。茯砖茶是在特定条件下经“发花”工艺加工而成的黑茶。在“发花”过程中,冠突散囊菌大量增殖形成金黄色菌落(即为“金花”)。其分泌多酚氧化酶、淀粉酶、纤维素酶、果胶酶等多种胞外酶,促进茶叶成分的转化,产生色素和多种活性代谢物,从而提高黑茶的色泽和香气,改善茶的品质、滋味和生物学活性。除茯砖茶外,冠突散囊菌亦在藏茶、六堡茶、陕西茯茶等多种黑茶中发现,且有效参与了黑茶的风味形成过程。此外,茶来源的冠突散囊菌具有调节血糖、调节肠道菌群、降血脂及减肥等功效,被认为是益生菌,被用于大豆、燕麦、三七等的生物转化。冠突散囊菌固态发酵大豆后,糖类物质持续下降,总蛋白和总黄酮含量呈先升高后下降的趋势,挥发性成分也发生明显变化;发酵后的大豆能促进小鼠的排便。以冠突散囊菌发酵燕麦,发酵过程中多酚含量与多酚氧化酶、阿魏酸酯酶和苯丙氨酸解氨酶的活性密切相关;发酵后燕麦的抗氧化能力大幅提升。冠突散囊菌发酵后的三七,其三七皂苷含量显著提高,体外抗氧化、降血糖能力增强。
苦荞含有丰富的蛋白质、淀粉、脂肪等基本营养成分,且为富含多酚及黄酮类化合物等活性成分的药食两用作物,具有抗氧化、抗衰、降糖和降脂等保健功能。苦荞蛋白的生物利用率高,含有谷蛋白、清蛋白、球蛋白等多种组分,营养价值高。其淀粉中直链淀粉占 20%~38%,支链淀粉占 12%~13%。苦荞的脂肪含量为 2.1%~2.5%,其中包括油酸和亚油酸在内的不饱和脂肪酸占总脂肪酸含量的 70% 以上,是人体的必需脂肪酸,还能有效促进幼儿的生长发育。苦荞富含黄酮和多酚类化合物,主要有芦丁、槲皮素、山奈酚、山奈酚-3-O-芸香糖苷、槲皮苷等,其中芦丁的含量占总黄酮的 80% 左右。黄酮和多酚类化合物具有降“三高”、抗氧化、预防心血管疾病等功效。近年来,随着大健康产业的快速发展,苦荞类功能产品的需求激增,但已有的苦荞产品存在加工工艺单一、种类简单化和低值化等问题。因此,基于益生菌发酵等新工艺研发新型苦荞产品具有重要的现实意义。
为有效利用苦荞的营养和功能价值,丰富苦荞加工产品的种类,本文拟研究冠突散囊菌对苦荞的生物转化过程。从不同市售黑茶中分离和鉴定冠突散囊菌,并固态发酵苦荞籽粒,通过测定发酵前后产物的总淀粉、还原糖、可溶性蛋白、脂肪等营养物质,功能成分总黄酮和总多酚的含量,以及两种重要生物转化酶(苯丙氨酸解氨酶和多酚氧化酶)的活性,分析不同冠突散囊菌对苦荞营养功能成分的转化作用,以期为新型苦荞发酵产品的开发提供理论依据。
结果与分析
2.1 菌株的形态特征和表征鉴定
采用稀释涂布法从 8 种市售黑茶中分离优势真菌。每种黑茶中各分离出一株金黄色候选真菌,共8 株,分别命名为 SH(三鹤菌)、LB(六堡菌)、JM(金叶蔓子菌)、JW(泾渭菌)、AH(安化菌)、TZ(特制菌)、YZ(雅安藏茶菌)及 JY(泾阳菌)。分离菌株在PDA 培养基上生长 5 d 的菌落形态见图 1,不同来源冠突散囊菌候选菌的生长形态特征与菌落形态存在较大差异。菌株 SH、JM、JW 和 AH 在 PDA 培养基上菌丝呈针状散射形,菌落边缘呈规则锯齿状;菌株 LB、YZ、TZ 和 JY 在 PDA 培养基上菌落呈绒状。8 株菌株的菌落形态大同小异,内圈呈棕褐色,外圈呈淡黄色。TZ 菌株在 5 d 已产生较多黑褐色液体(图 1E)。培养基的营养成分、渗透压及 pH 等因素都会影响冠突散囊菌的生长情况和生殖方式。
培养基的渗透压会影响冠突散囊菌的生殖方式,当渗透压低时,冠突散囊菌呈有性生殖;当渗透压高时,冠突散囊菌呈无性生殖。参考《真菌鉴定手册》和《中国真菌志 第 5 卷》,初步推断菌株 SH、LB、JM、JW、TZ、AH、YZ 及 JY 可能为冠突散囊菌候选菌株。

黄酮类化合物是苦荞的重要活性物质。冠突散囊菌固态发酵能提高发酵体系的黄酮类化合物含量,其固态发酵葡萄渣籽和豆类后,体系总黄酮的含量和抗氧化能力均显著提高。为比较不同黑茶来源冠突散囊菌的生物转化效果,将 7 株分离菌株分别接种苦荞籽粒并固态发酵 10 d。同时接种AH 菌株,以比较不同菌种的转化效果。发酵前后苦荞中总黄酮和总多酚的含量变化如图 3 所示,经不同菌发酵后,苦荞籽粒中总黄酮含量的浓度范围在10.16±0.47~14.44±0.30 mg/g(图 3E),除 JM 组与未发酵组差异不明显外,其余组含量较未发酵组(10.02±0.12 mg/g)均有显著提高(P<0.05)。其中,经菌株 LB、AH 和 YZ 发酵的苦荞籽粒中总黄酮含量增加最显著,分别达 14.37±0.75、13.70±0.57 和 14.44±0.30 mg/g,较未发酵苦荞籽粒分别提高了 43.41%、36.73% 和 44.11%。多酚类化合物是苦荞的重要活性成分之一,具有抗氧化和降血糖等功效。8 种菌发酵苦荞籽粒前后的总多酚含量范围为 10.48±0.54~16.34±0.70 mg/g(图 3F)。其中,经菌株 JW 和YZ 发酵的苦荞籽粒中总多酚含量增加最显著,分别达 16.34±0.70 mg/g 和 16.05±0.46 mg/g,较未发酵苦荞籽粒(11.40±0.38 mg/g)分别提高了 43.33% 和40.79%;而经菌株 JY 发酵的苦荞籽粒中总多酚含量显著低于其他发酵组(P<0.05),与未发酵组差异不明显。样品总多酚含量从高到低依次是 JW>YZ>TZ>LB>AH>SH>JM>CK>JY。因此,苦荞籽粒总黄酮和总多酚的含量经发酵后在不同菌株间存在显著差异,且经冠突散囊菌发酵后,多数菌株发酵后呈现上调趋势。植物富含多酚类化合物,但可溶性游离酚含量较少。大部分多酚类化合物是与细胞壁上的糖类和蛋白质等成分共价结合,以不溶性结合酚形式存在。固态发酵过程中,冠突散囊菌会分泌丰富的水解酶,催化细胞壁结构成分和不溶性结合酚类之间的共价键的水解,促进可溶性多酚的释放。此外,微生物的代谢活动和酶促反应能促进多酚类物质的代谢生成,从而提高总多酚的含量。从图 3 可知,AH菌株虽为谢瓦氏曲霉,但其对苦荞黄酮和多酚亦有较好的转化效果。

苯丙氨酸解氨酶是苯丙烷类化合物生物合成途径中的关键限速酶,其催化 L-苯丙氨酸经非氧化脱氨基作用生成反式肉桂酸,将碳通量从初级代谢途径分流引导至反式肉桂酸合成途径,再进一步转化为不同的次级代谢物,包括黄酮类化合物、木质素及生物碱等。如图 4A 所示,不同菌株发酵体系中苯丙氨酸解氨酶的活性差异较明显。发酵组的苯丙氨酸解氨酶活力范围为 6.67±1.40~98.06±7.94 U/(g·h),其中,经菌株 YZ 发酵后的最高,其次为 JW,显著高于其他菌株(P<0.05)。各组苯丙氨酸解氨酶的活力值从 高 到 低 分 别 是 YZ>JW>LB>TZ>AH>SH>JM>JY>CK。多酚氧化酶是广泛存在植物中的三型铜氧化还原酶,也是参与多种酚类物质交联聚合形成的活性酶,其通过单羟基酚羟基化生成邻位双酚,再氧化成醌类化合物,与蛋白质和氨基酸聚合形成黑色素。研究表明,植物中多酚氧化酶活性与多酚含量呈正相关。不同菌株发酵后体系中多酚氧化酶的活性差异明显(图 4B)。发酵组的多酚氧化酶活力范围在7.47±2.00~34.66±3.09 U/(g·min)之间。其中,经菌株 YZ 发酵后体系多酚氧化酶活力最高,其次为 TZ,菌株 JY 的最低。各体系中多酚氧化酶活力值从高到低依次是 YZ>TZ>JW>AH>JM>LB>SH>JY>CK。未发酵组均未检测出酶活性,可能是高温高压灭菌处理有效杀灭了苦荞籽粒本身的酶活性。因此,发酵后的苦荞的黄酮含量提高可能与菌株中苯丙氨酸解氨酶的活性密切相关。分析 NCBI 数据库中的冠突曲霉的基因组数据,发现其中含有潜在的苯丙氨酸解氨酶(Accession:ODM22472.1)和酚氧化酶(Accession:ODM14462.1)基因。冠突散囊菌在生长和发酵期间能产生大量的黑色素,如图 1 所示,推测这可能与其酚氧化酶的酶活性密切相关。黑色素具有抗氧化、抗辐射、抗菌等功能,可进一步提高苦荞的生物学活性。与转化黄酮和多酚等营养成分的效果类似,AH 菌株亦表现出与冠突散囊菌类似的苯丙氨酸解氨酶活性和多酚氧化酶活性,进一步验证了黑茶来源的冠突散囊菌与谢瓦氏曲霉的相似性。此外,谢瓦氏曲霉的基因组中也发现有苯丙氨酸解氨酶(Accession:XP_043131183.1)和酚单氧化酶(Accession:XP_043138668.1)候选基因的存在。因此,黑茶来源的两种“金花”菌在茶叶等基质的生物转化过程中的异同点值得通过比较基因组学、功能基因组学、比较转录组学等方法进行进一步研究。

为分析发酵前后苦荞籽粒营养成分的变化是否与冠突散囊菌的酶催化作用相关,分析了苦荞籽粒的营养成分之间以及与苯丙氨酸解氨酶和多酚氧化酶的酶活力之间的相关性,如图 5 所示。结果发现,苯丙氨酸解氨酶和多酚氧化酶活力、总黄酮与总多酚含量呈极显著正相关(相关性系数皆大于 0.6,且P<0.001),而总淀粉含量与还原糖含量呈极显著负相关(相关性系数为−0.96,且 P<0.001)。提示发酵后苦荞营养成分的变化与冠突散囊菌酶活力密切相关。冠突散囊菌基因组中发现有苯丙氨酸解氨酶和酚氧化酶的编码基因,以及丰富的纤维酶、淀粉酶、蛋白酶和脂肪酶相关基因。谷物中大多数酚类化合物是通过醚、酯或糖苷键等化学键与细胞壁结构成分共价结合,以不溶的结合形式存在,难以提取;仅有少量的酚类化合物是以简单、可溶性游离酯的形式存在。在固态发酵过程中,微生物(尤其是真菌)可以分泌多种水解醚、酯或糖苷键的酶,有效作用于细胞壁结构,从而促进细胞壁中不溶性化合物的释放,进而提高了谷物制品的生物学活性。研究显示,多种丝状真菌在固态发酵豆谷类时 β-糖苷酶表现活跃,如泡盛曲霉、米曲霉、安康曲霉、酱油曲霉、冠突曲霉等。因此,冠突散囊菌发酵后总黄酮和多酚类化合物含量的提高,一方面可能是因为苯丙氨酸解氨酶促进了黄酮类化合物的合成,另一方面可能是菌分泌的胞外水解酶(如纤维素酶、淀粉酶、酚氧化酶等)有效促进了酚类物质从发酵基质中的释放。因此,冠突散囊菌固态发酵是改善植物生物活性成分,并制备具有优异生物活性的苦荞产品/成分的一种有效方法。

结论与展望

引用本文:刘姝琪,郑浩楠,辛园,等. 不同黑茶来源冠突散囊菌的分离鉴定及其固态发酵对苦荞营养功能成分的影响[J]. 食品工业科技,2025,46(11):132−141. doi: 10.13386/j.issn1002-0306.2024050324.
Citation: LIU Shuqi, ZHENG Haonan, XIN Yuan, et al. Isolation and Identification of Eurotium cristatum from Different Dark Tea Sources and the Effect of Solid-state Fermentation on the Nutritional and Functional Components of Tartary Buckwheat[J]. Science and Technology of Food Industry, 2025, 46(11): 132−141. (in Chinese with English abstract). doi: 10.13386/j.issn1002-0306.2024050324 .
基金项目:四川省科技厅项目(No. 2022NSFSC1706);国家自然科学基金项目(No. 32302083);2024年中央“三区”科技人才支持计划(川财教[2024]70号);成都大学教改项目(No. cdsyjg2022047)。
通信作者简介

姜良珍,女,成都大学食品与生物工程学院副教授,硕士生导师。主要研究方向:微生物合成生物学、药食同源植物营养和功能因子的挖掘。主要科研和教学:主要开展人工智能结合的微生物合成生物学、潜力微生物资源的开发和应用、药食同源植物营养和功能因子的挖掘等研究工作。承担本科生《生物工程研究进展》、《生物化学》、《细胞工程》、《微生物学》、《生产实习》和《生物化学实验》等课程的教学。
(以上信息来自成都大学官网)
或登录www.spgykj.com阅览全文。
荟聚食品英才,
共创美好未来
各位专家学者:
为推动食品科学领域的知识经验交流,促进食品产业的创新发展,2025第三届食品科学家论坛及产学研交流大会、2025宁夏食品科学论坛暨《食品工业科技》与 Food Innovation and Advances 编委会会议将于2025年8月4-6日在银川召开。本次论坛将以“荟聚食品英才,共创美好未来”为主题,旨在为食品科学家提供交流平台,加强技术交流和创新能力融合。
本届论坛拟邀请食品科学领域研究机构的多位专家学者,围绕基础研究领域的前沿进展、产业发展最新动态,展开深入的学术交流与探讨。同时,我们将就未来的合作和交流平台建设进行对话,总结经验、传播知识、思考未来,共同推动食品科技创新和可持续发展。
食品科学家是推动食品学科发展、产业进步的中坚力量,而青年科学家是重要力量。本次论坛诚挚邀请国内外各大院校、科研院所、食品企业等专家共同参与,期待食品科学家、青年科学家、博士研究生、硕士研究生积极提交研究成果,分享研究心得,共同推动食品学科的发展。本届论坛不仅为国内外食品学科领域的交流与合作提供了平台,也将为食品期刊、食品饮料企业、仪器商提供展览、展示。Food Junction:2025第三届食品科学家论坛及产学研交流大会期待与您相约“塞上江南”——银川。
点击链接进行注册:2025第三届食品科学家论坛及产学研交流大会、2025宁夏食品科学论坛暨食品工业科技与FIA编委会会议——回执表.docx
点击链接下载邀请函:邀请函—2025第三届食品科学家论坛及产学研交流大会.pdf
食品科学家论文汇总
(点击专家姓名,查看论文)
《食品工业科技》特邀主编专栏征稿
《食品工业科技》客座主编专栏征稿:地方特色食品:加工技术、感官品质、风味特性和营养健康☚
《食品工业科技》特邀主编专栏征稿:“十四五”国家重点研发计划“陕西秦巴山区特色经济作物、果蔬产业关键技术集成与示范”☚
《食品工业科技》特邀主编专栏征稿:果蔬基料制造:基础理论,新型加工、质量控制与智能制造☚
群聊:食品工业科技作者群
温
馨
提
示
我刊正式组建微信作者群,为作者提供更多的学术与论文资讯,如需进群,请联系刘老师(微信:上方二维码,电话:87244117-8062)。
版权声明

